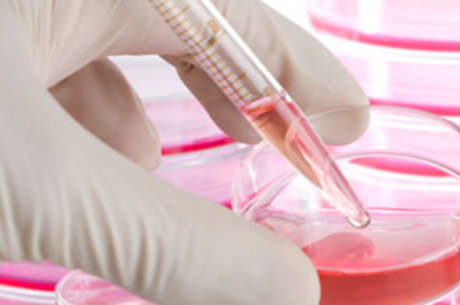

Os primeiros testes em macacos de uma vacina contra o vírus HIV, causador da
AIDS, produziram resultados surpreendentes. O experimento é desenvolvido por
pesquisadores da Universidade de São Paulo.
O que há 30 anos parecia um sonho quase impossível está deixando de ser. Com
os avanços no conhecimento genético do vírus HIV, a vacina contra a AIDS começou
a ser pesquisada no Brasil, em 2002, nos laboratórios do instituto do coração de
São Paulo e da faculdade de medicina da USP e no instituto Butantan.
O HIV é um vírus que ataca o sistema imunológico. O desafio era descobrir
fragmentos do vírus que pudessem ser identificados e atacados pelo próprio
sistema de defesa do organismo. E os pesquisadores descobriram, em amostras de
sangue de humanos, 18 fragmentos reconhecíveis do vírus HIV, o que abriu caminho
para a criação da vacina.
Os cientistas estudaram pacientes com o vírus mas que não desenvolveram a
doença. “Esses indivíduos são aqueles que sabem se defender em contra o vírus,
sabe de defender bem naturalmente contra o vírus e nós fomos estudar o detalhe
da resposta imune contra o vírus e aí que nós desenhamos a vacina”, diz Jorge
Kalil, diretor do Instituto Butantan.
A primeira vacina experimental surgiu quatro anos depois da pesquisa e
inicialmente ela foi testada em camundongos. E a resposta dos ratinhos foi muito
positiva, tanto que a pesquisa seguiu avançando e uma nova vacina foi
sintetizada e, em novembro do ano passado, ela foi testada pela primeira vez em
macacos resus, que são um tipo de macaco muito utilizado em pesquisas
cientificas. O resultado foi surpreendente. O sistema de defesa dos macacos
reagiu de 5 a 10 vezes melhor que a dos camundongos.
O teste com os camundongos foi publicado em junho de 2010 na revista Plos
One, uma referência na área de pesquisa científica e inovação.
Os resultados com os macacos são decisivos porque os primatas são muito
próximos do ser humano.
“O primeiro teste em humanos ele é muito simples, ele é baseado em pessoas
que tem baixo risco e é só para a gente saber se a vacina é segura e se ela
desencadeou uma resposta imune. Pelo andar da carruagem, provavelmente em 3 anos
vamos começar esses testes”, aponta Edecio Cunha Neto, pesquisador da Fac.
Medicina da USP.
A corrida por uma vacina definitiva contra a AIDS é mundial. A doença que
apavorou o mundo é hoje uma das mais estudadas. Cura? Ainda não. Vacina? Bem
mais provável.
Cientistas da USP anunciam resultados positivos de vacina contra AIDS
Publicação por: Grupo Contra o Preconceito on 11:50. - No comments




0 comentários:
Postar um comentário